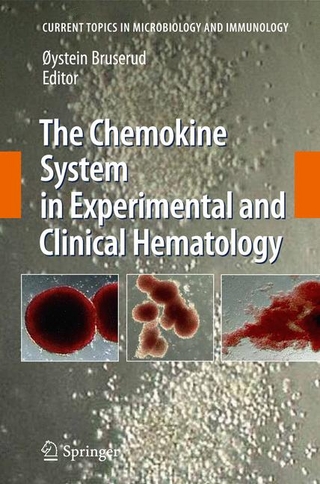
The Chemokine System in Experimental and Clinical Hematology

Why Hypovolemic Dehydration Can Explain the Real Physiological Basis of So-Called Psychogenic Water Drinking
Buch | Softcover
2025
|
Patrick Ussher
ISBN: 9780947874087
CHF 17,40 (inkl. MwSt)
- Versand in
10-20 Tagen